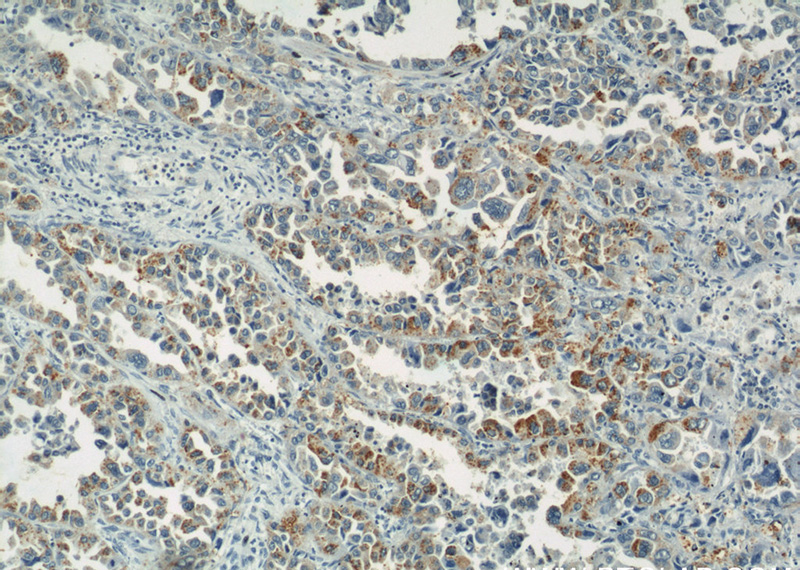
Immunohistochemical of paraffin-embedded human lung cancer using Catalog No:112277(LAMP2 antibody) at dilution of 1:50 (under 10x lens)
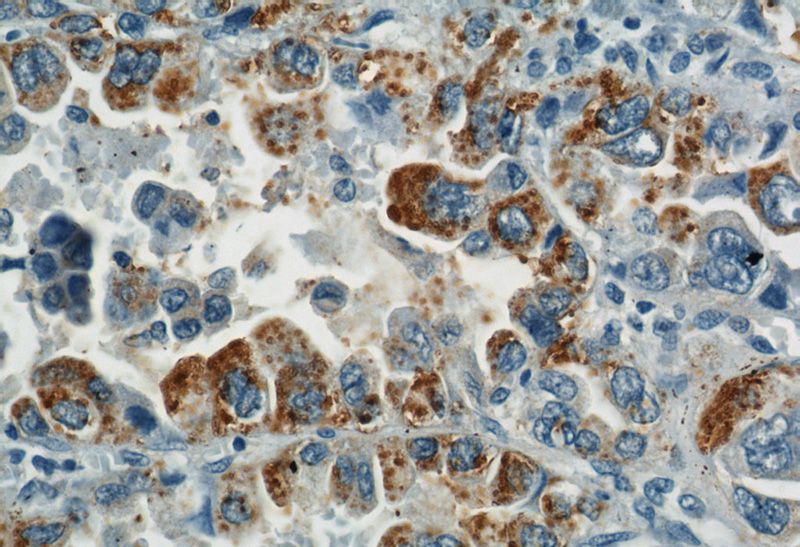
Immunohistochemical of paraffin-embedded human lung cancer using Catalog No:112277(LAMP2 antibody) at dilution of 1:50 (under 40x lens)

-
Product Name
LAMP2 antibody
- Documents
-
Description
LAMP2 Rabbit Polyclonal antibody. Positive IF detected in HepG2 cells. Positive IHC detected in human lung cancer tissue, human colon cancer tissue, human placenta tissue, human skeletal muscle tissue. Positive FC detected in HepG2 cells. Positive WB detected in L02 cells, HEK-293 cells, HeLa cells, HepG2 cells, HT-1080 cells, human placenta tissue, K-562 cells, mouse kidney tissue, mouse skeletal muscle tissue, NIH/3T3 cells, RAW 264.7 cells. Observed molecular weight by Western-blot: 50-55 kDa
-
Tested applications
ELISA, WB, IF, FC, IHC
-
Species reactivity
Human, Mouse; other species not tested.
-
Alternative names
CD107b antibody; LAMP 2 antibody; LAMP2 antibody; LAMPB antibody; LGP110 antibody
-
Isotype
Rabbit IgG
-
Preparation
This antibody was obtained by immunization of LAMP2 recombinant protein (Accession Number: NM_013995). Purification method: Antigen affinity purified.
-
Clonality
Polyclonal
-
Formulation
PBS with 0.1% sodium azide and 50% glycerol pH 7.3.
-
Storage instructions
Store at -20℃. DO NOT ALIQUOT
-
Applications
Recommended Dilution:
WB: 1:200-1:1000
IHC: 1:50-1:500
IF: 1:10-1:100
-
Validations

L02 cells were subjected to SDS PAGE followed by western blot with Catalog No:112277(LAMP2 antibody) at dilution of 1:300
Immunohistochemical of paraffin-embedded human lung cancer using Catalog No:112277(LAMP2 antibody) at dilution of 1:50 (under 10x lens)
Immunohistochemical of paraffin-embedded human lung cancer using Catalog No:112277(LAMP2 antibody) at dilution of 1:50 (under 40x lens)

Immunofluorescent analysis of HepG2 cells, using LAMP2 antibody Catalog No:112277 at 1:25 dilution and Rhodamine-labeled goat anti-rabbit IgG (red).

1X10^6 HepG2 cells were stained with .2ug LAMP2 antibody (Catalog No:112277, red) and control antibody (blue). Fixed with 90% MeOH blocked with 3% BSA (30 min). Alexa Fluor 488-congugated AffiniPure Goat Anti-Rabbit IgG(H+L) with dilution 1:1000.
-
Background
Lysosomal-associated membrane protein 2 (LAMP2, synonyms: LAMPB, CD107b) is a member of a family of membrane glycoproteins. This glycoprotein provides selectins with carbohydrate ligands. LAMP2 may plays a role in tumor cell metastasis. It may also functions in the protection, maintenance, and adhesion of the lysosome. Prior to posttranslational modification, LAMP2 is a ~45 kDa polypeptide. Mature, functional LAMP2 is extensively glycosylated with a variety of different N linked and O linked oligosaccharides.
-
References
- Alatrash G, Ono Y, Sergeeva A. The role of antigen cross-presentation from leukemia blasts on immunity to the leukemia-associated antigen PR1. Journal of immunotherapy (Hagerstown, Md. : 1997). 35(4):309-20. 2012.
- Yao XF, Cao J, Xu LM. Perfluorooctane sulfonate blocked autophagy flux and induced lysosome membrane permeabilization in HepG2 cells. Food and chemical toxicology : an international journal published for the British Industrial Biological Research Association. 67:96-104. 2014.
- Wang M, Zhao D, Yang Y. The cellular prion protein negatively regulates phagocytosis and cytokine expression in murine bone marrow-derived macrophages. PloS one. 9(7):e102785. 2014.
- Zhang L, Zhang W, Wang YF. Dual induction of apoptotic and autophagic cell death by targeting survivin in head neck squamous cell carcinoma. Cell death & disease. 6:e1771. 2015.
Related Products / Services
Please note: All products are "FOR RESEARCH USE ONLY AND ARE NOT INTENDED FOR DIAGNOSTIC OR THERAPEUTIC USE"
